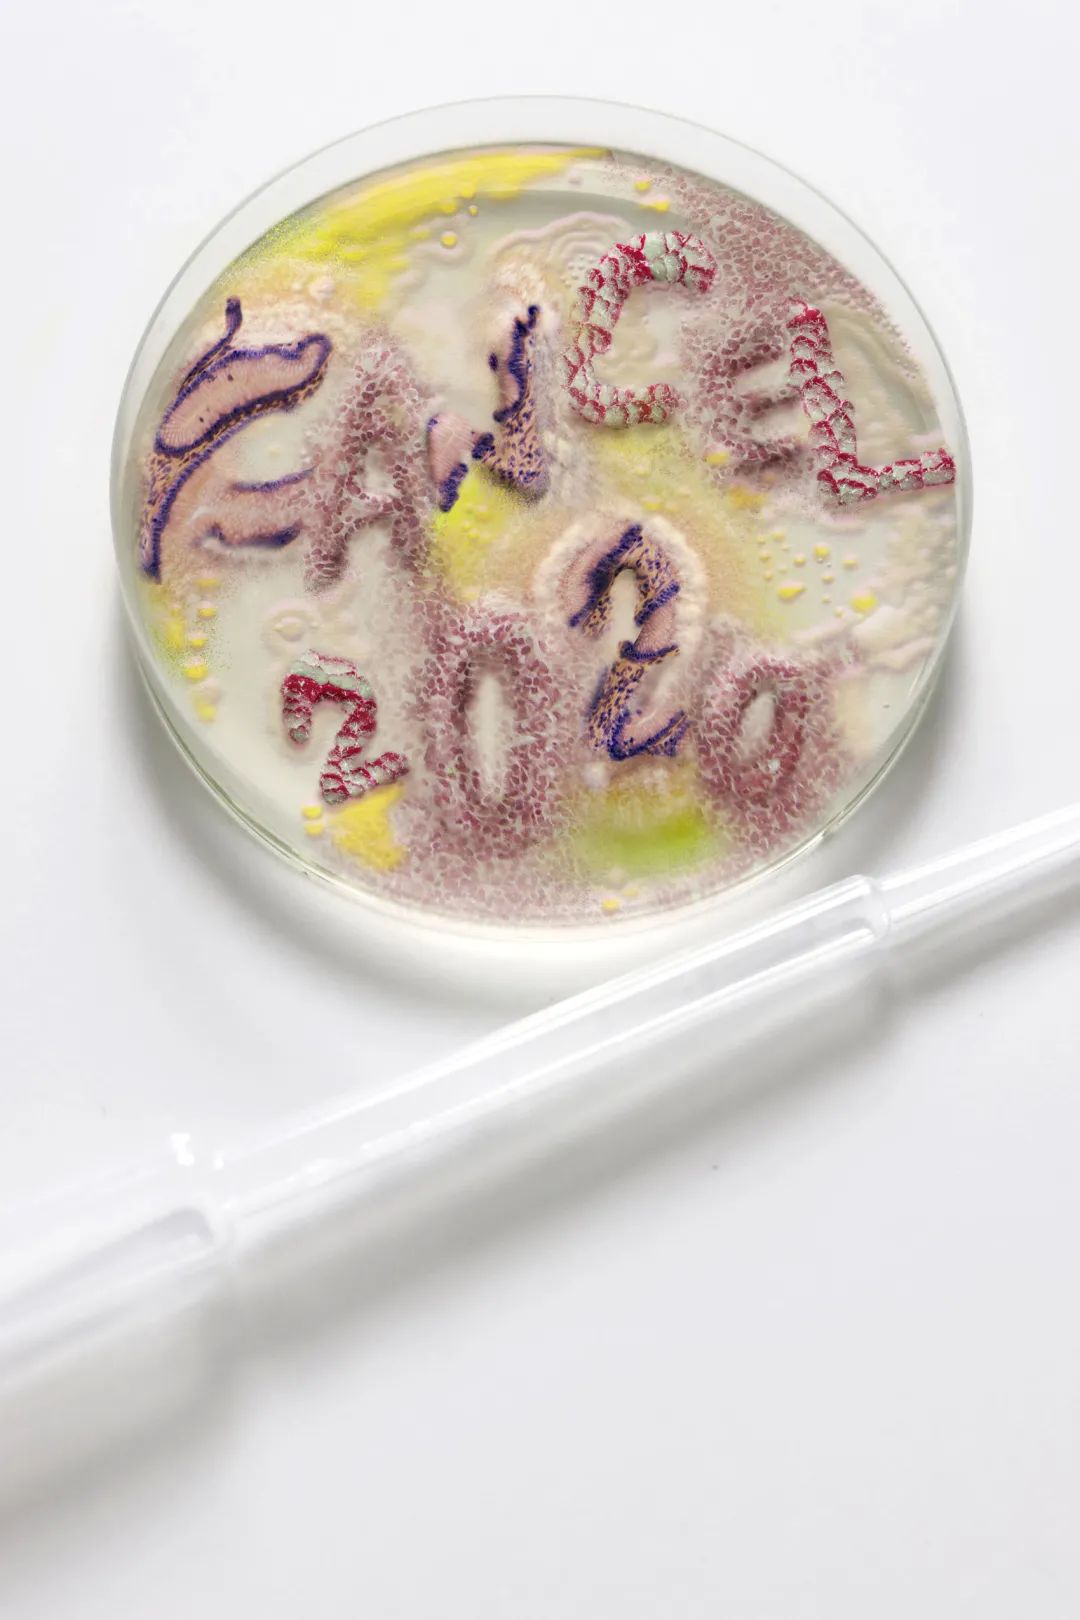

- 0
- 0
- 0
分享
- 绘画丨2021世界插画奖获奖揭晓!从历届全场大奖看起
-
2022-01-08
本文转自:Hiiibrand

世界插画奖是对全球插画家开放的最负盛名的年度评审比赛,该奖项由插画师协会(AOI, The Association of Illustrators)与插画目录(DI,Directory of Illuatration)共同举办。
1975年,AOI首次举办名为“Images”的年度插画竞赛,对全英国插画师开放;2012年,该赛事更为“AOI插画奖”;2015年,AOI与DI(美国插图目录)建立合作,并正式创立现在的世界插画奖。
WIA 2015
全 场 大 奖
Jessica Bromley Bartram

Olivier Kugler

WIA 2016
全 场 大 奖
Jimin Kim
Jungho Lee
WIA 2017
全 场 大 奖
Aart-Jan Venema

Marco Palena

WIA 2019
全 场 大 奖
Anna Mill
Connectivity
Patrick Dias
WIA 2020
全 场 大 奖
Women In The Workplace
Amber Vittoria
Flooded
Mariajo Ilustrajo
2021届获奖公布
本届奖项类别
◆ 全场大奖(Overall Winners)
◆ 组别优胜奖(Category Winners)
类目:广告、另类读物、书籍封面、儿童出版物、商业出版、产品设计及包装、编辑类插画、探索、科技、特定项目
01.
全场大奖
OVERALL WINNER
专业组 / 编辑类插画
The Other US Epidemic
Fatinha Ramos

新锐组 / 产品设计及包装
Cabinet of Curiosities
Dani Choi

02.
组别优胜奖
Category Winner
类目一:广告
Minari Movie Postcards
Sojung Kim-McCarthy / 专业组
[more]
Marie Doerfler / 新锐组
类目二:另类读物
From London, Heading South: A Zine
Amy Moss / 专业组
Living with Endometriosis
Justyna Green / 新锐组
类目三:书籍封面
I Know Why the Caged Bird Sings
Shabazz Larkin / 专业组

The Night Manager
Ioana Bolchis / 新锐组


类目四:儿童出版物
I am the Subway
Kim Hyo-Eun / 专业组
Mai
Dide Tengiz / 新锐组
类目五:商业出版
The Book of Trespass
Nick Hayes / 专业组
Cain and Abel
Katie Bullimore / 新锐组
类目六:产品设计及包装
New World poster series
Zamo Peza / 专业组
Cabinet of Curiosities
Dani Choi / 新锐组

类目七:编辑类插画
The Other US Epidemic
Fatinha Ramos / 专业组

Collection
Jialei Sun / 新锐组
类目八:探索
Morphing Shadow
Maryam Khaleghiyazdi / 专业组

Portraits of Westlake
Dominic Bodden / 新锐组
类目九:科技
Earth's Processes
Victoria Nakada / 专业组
Sustainability Awareness Posters
Tabitha Wall / 新锐组
类目十:特定项目
Workings Of Sheffield
Willustration / 专业组
Interactive Educational Path - Salföld Manor
Tímea Zsófia Terenyei / 新锐组
03.
AOI会员奖
AOI Members Award
新锐组 / 探索
Days Spent in Isolation
Jason Chuang Art

04.
《插画目录》奖
DI Award
专业组 / 探索
Personal exploration
Iris de Luz


05.
推荐奖
Highly Commended
类目一:广告
Lockdown Cat Series
Myriam Wares / 专业组
New Millennium stop motion music video animation
Cecilia Abeid / 新锐组

类目二:另类读物
Body and Soul
Antonio Sortino / 专业组

Wildlife
Daniela Sosa / 新锐组
类目三:书籍封面
The Deptford Trilogy
Karolis Strautniekas / 专业组
Macbeth
Gaptoof / 新锐组

类目四:儿童出版物
It isn't Rude to be Nude
Rosie Haine / 专业组


Meat Thief
Chia-Ni Wu / 新锐组

类目五:商业出版
Stories for Book Lovers
Natalia Zaratiegui / 专业组


"The Outsider" by Albert Camus
Pavlena Mateeva / 新锐组

类目六:编辑类插画
Karolis Strautniekas
Karolis Strautniekas / 专业组

Contagion Fables
Karolis Strautniekas / 新锐组

类目七:产品设计及包装
Biotherm limited edition
Carlos Arrojo / 专业组

Eco Croc
Laura Oh / 新锐组

类目八:探索
Wine Time (Corona)
Nina Bachmann / 专业组




Days Spent in Isolation
Jason Chuang Art / 新锐组

类目九:科学
Lise Meitner Project
Elena Resko / 专业组


What's In Us
Wenjing Yang / 新锐组

类目十:特定项目
Wet Paint - A social experiment in social distancing
Curious Lauren / 专业组




Lucky Cat Noodle Spatial Design, Murals and Visual Communication
Estée Angéline / 新锐组



06.
创新奖
Innovation Award
专业组 / 科技
Typographic Bacteria
Xavier Segers

07.
SAA奖
SAA Award
新锐组 / 产品设计与包装
Silk Road Wonders
Grace Park




责编:成海
-
阅读原文
* 文章为作者独立观点,不代表数艺网立场转载须知
- 本内容由数艺网主动采集收录,信息来源为 “中国舞台美术学会” 公开网络发布内容。第三方如需转载本内容,必须完整标注原作者信息及 “来源:数艺网”,严禁擅自篡改、删减或未标注来源转载。 并附上本页链接: 若您的内容不希望被数艺网收录,或认为此举侵犯了您的合法权益,敬请通过微信 ID:d-arts-cn 联系数艺网。我们将致以诚挚歉意,并第一时间为您办理下架或删除处理。




















































































































